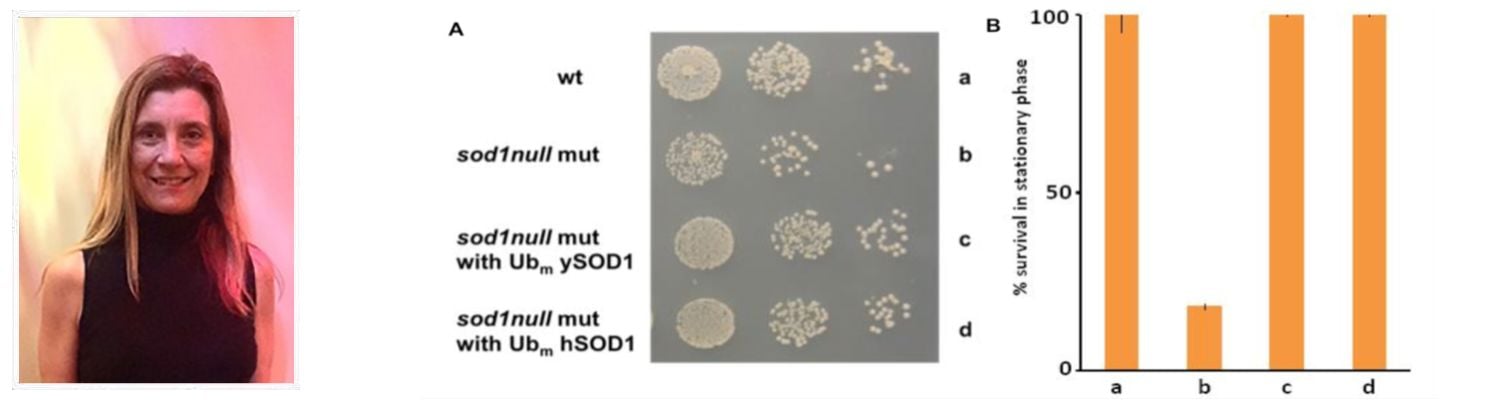
Hero 2.png

Research Focus

The research in the Mandon laboratory is devoted to understanding the role of mitochondria and the endoplasmic reticulum in neurodegeneration and aging. These organelles are early targets during the onset of neurodegenerative diseases such as amyotrophic lateral sclerosis (ALS) Alzheimer's, Parkinson's, and Huntington's disease, and their damages contribute significantly to disease progression. Mitochondrial damage and dysfunction are also heavily involved in the aging process. Research in the Mandon laboratory focuses on two fundamental areas. First, the determination of the early events that trigger mitochondrial and endoplasmic reticulum damages and second, the elucidation of the mechanisms that underlie organelle dysfunction in the pathogenesis of human neurodegenerative diseases and in the aging process.
This work is funded through a collaborative grant with Dr. Oliver Rando.
Publications

Conserved motifs on the cytoplasmic face of the protein translocation channel are critical for the transition between resting and active conformations.
Mandon EC, Butova C, Lachapelle A, Gilmore R.
J Biol Chem. 2018 Aug 31;293(35):13662-13672
Structural basis for coupling protein transport and N-glycosylation at the mammalian endoplasmic reticulum.
Braunger K, Pfeffer S, Shrimal S, Gilmore R, Berninghausen O, Mandon EC, Becker T, Förster F, Beckmann R.
Science. 2018 Apr 13;360(6385):215-219
Follow our research, stay in touch – join the lab!
Twitter Feed
Contact Us
Office:
Albert Sherman Center
Phone:
508-856-6051 (office)
Email:
Elisabet.Mandon@umassmed.edu
Mailing Address:
UMass Chan Medical School
Attn: Dr. Elisabet Mandon
Horae Gene Therapy Center
368 Plantation St.
Worcester, MA 01605
Join Us
We are always interested in applications from qualified candidates at postdoctoral and research associate levels.
Read more here
Undergraduates interested in pursuing a PhD at UMass Chan Medical School should apply directly to the Morningside Graduate School of Biomedical Sciences Program.